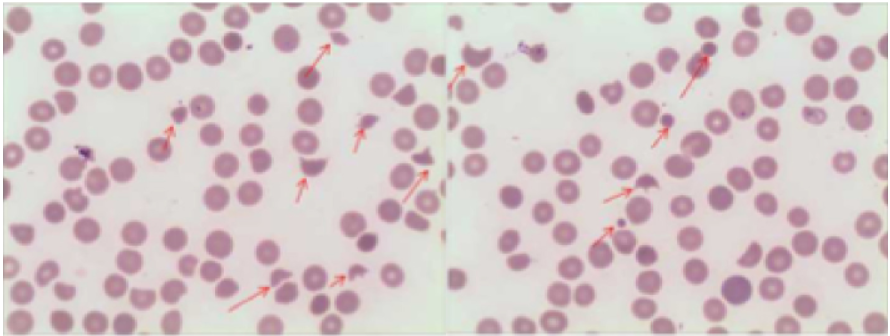
gln30-s5

HemaBook. –ď–Ľ–į–≤–į 4. –í—Ā–Ķ–≥–ī–į –Ľ–ł —ā—Ä–Ķ–Ī—É–Ķ—ā—Ā—Ź –Ņ–Ķ—Ä–Ķ–Ľ–ł–≤–į–Ĺ–ł–Ķ —ā—Ä–ĺ–ľ–Ī–ĺ—Ü–ł—ā–ĺ–≤ –Ņ—Ä–ł —ā—Ä–ĺ–ľ–Ī–ĺ—Ü–ł—ā–ĺ–Ņ–Ķ–Ĺ–ł–ł?
Mindray 2020-12-17

–Ē–Ķ–Ļ—Ā—ā–≤–ł—ā–Ķ–Ľ—Ć–Ĺ–ĺ –Ľ–ł —ā—Ä–Ķ–Ī—É–Ķ—ā—Ā—Ź –Ņ–Ķ—Ä–Ķ–Ľ–ł–≤–į–Ĺ–ł–Ķ —ā—Ä–ĺ–ľ–Ī–ĺ—Ü–ł—ā–ĺ–≤, –Ķ—Ā–Ľ–ł —Ā–ĺ–ī–Ķ—Ä–∂–į–Ĺ–ł–Ķ —ā—Ä–ĺ–ľ–Ī–ĺ—Ü–ł—ā–ĺ–≤ (PLT) —á—Ä–Ķ–∑–≤—č—á–į–Ļ–Ĺ–ĺ –Ĺ–ł–∑–ļ–ĺ–Ķ? –Ē–į–≤–į–Ļ—ā–Ķ –Ņ—Ä–ĺ–į–Ĺ–į–Ľ–ł–∑–ł—Ä—É–Ķ–ľ —Ā–Ľ–Ķ–ī—É—é—Č–ł–Ļ —Ā–Ľ—É—á–į–Ļ, –Ņ–ĺ–ī—Ä–į–∑—É–ľ–Ķ–≤–į—é—Č–ł–Ļ –ł–Ĺ–ĺ–Ļ –ĺ—ā–≤–Ķ—ā.
?
–ě—Ā–≤–Ķ—Č–Ķ–Ĺ–ł–Ķ –Ņ—Ä–ĺ–Ī–Ľ–Ķ–ľ—č
49-–Ľ–Ķ—ā–Ĺ—Ź—Ź –∂–Ķ–Ĺ—Č–ł–Ĺ–į –ĺ–Ī—Ä–į—ā–ł–Ľ–į—Ā—Ć –≤ –ĺ—ā–ī–Ķ–Ľ–Ķ–Ĺ–ł–Ķ –Ĺ–Ķ–ĺ—ā–Ľ–ĺ–∂–Ĺ–ĺ–Ļ –Ņ–ĺ–ľ–ĺ—Č–ł —Ā –∂–į–Ľ–ĺ–Ī–ĺ–Ļ –Ĺ–į —ā—Ä–į–Ĺ–∑–ł—ā–ĺ—Ä–Ĺ–ĺ–Ķ –ļ–ĺ–≥–Ĺ–ł—ā–ł–≤–Ĺ–ĺ–Ķ —Ä–į—Ā—Ā—ā—Ä–ĺ–Ļ—Ā—ā–≤–ĺ. –£ –Ĺ–Ķ–Ķ –Ī—č–Ľ–ł —Ź–≤–Ĺ–ĺ –≤—č—Ä–į–∂–Ķ–Ĺ–Ĺ—č–Ķ –Ņ—Ä–ł—Ā—ā—É–Ņ–ĺ–ĺ–Ī—Ä–į–∑–Ĺ—č–Ķ –≥–ĺ–Ľ–ĺ–≤–Ĺ—č–Ķ –Ī–ĺ–Ľ–ł, —ć–Ņ–ł–≥–į—Ā—ā—Ä–į–Ľ—Ć–Ĺ—č–Ķ –Ī–ĺ–Ľ–ł –ł —Ä–≤–ĺ—ā–į. –ö–Ę –ľ–ĺ–∑–≥–į –Ĺ–Ķ –≤—č—Ź–≤–ł–Ľ–į –Ĺ–ł–ļ–į–ļ–ł—Ö –į–Ĺ–ĺ–ľ–į–Ľ–ł–Ļ. –†–Ķ–∑—É–Ľ—Ć—ā–į—ā—č –Ľ–į–Ī–ĺ—Ä–į—ā–ĺ—Ä–Ĺ—č—Ö –ł—Ā—Ā–Ľ–Ķ–ī–ĺ–≤–į–Ĺ–ł–Ļ –Ņ–ĺ–ļ–į–∑–į–Ľ–ł –Ĺ–į–Ľ–ł—á–ł–Ķ –į–Ĺ–Ķ–ľ–ł–ł –ł —ā—Ź–∂–Ķ–Ľ–ĺ–Ļ —Ą–ĺ—Ä–ľ—č —ā—Ä–ĺ–ľ–Ī–ĺ—Ü–ł—ā–ĺ–Ņ–Ķ–Ĺ–ł–ł. –ß–Ķ–≥–ĺ —Ā–Ľ–Ķ–ī—É–Ķ—ā –ĺ–∂–ł–ī–į—ā—Ć?
?

–ź–Ĺ–į–Ľ–ł–∑ –ļ—Ä–ĺ–≤–ł
–ź–Ĺ–į–Ľ–ł–∑ –ļ—Ä–ĺ–≤–ł (–†–ł—Ā.?1) –Ņ–ĺ–ļ–į–∑–į–Ľ –Ĺ–ł–∑–ļ–ĺ–Ķ —Ā–ĺ–ī–Ķ—Ä–∂–į–Ĺ–ł–Ķ —ć—Ä–ł—ā—Ä–ĺ—Ü–ł—ā–ĺ–≤ (RBC) (3,07√ó1012/–Ľ) –ł –Ĺ–ł–∑–ļ–ł–Ļ –≥–Ķ–ľ–ĺ–≥–Ľ–ĺ–Ī–ł–Ĺ, —á—ā–ĺ —É–ļ–į–∑—č–≤–į–Ķ—ā –Ĺ–į –į–Ĺ–Ķ–ľ–ł—é. –°–ĺ–ī–Ķ—Ä–∂–į–Ĺ–ł–Ķ PLT-O —Ā–ĺ—Ā—ā–į–≤–ł–Ľ–ĺ 15√ó109/–Ľ (—Ä–Ķ–∂–ł–ľ CDR, Mindray BC-6200). –°—ā–ĺ–Ľ—Ć –Ĺ–ł–∑–ļ–ĺ–Ķ —Ā–ĺ–ī–Ķ—Ä–∂–į–Ĺ–ł–Ķ PLT –ł –į–Ĺ–ĺ–ľ–į–Ľ—Ć–Ĺ—č–Ķ –Ņ–į—Ä–į–ľ–Ķ—ā—Ä—č RBC –Ņ—Ä–ł–≤–Ľ–Ķ–ļ–Ľ–ł –Ĺ–į—ą–Ķ –≤–Ĺ–ł–ľ–į–Ĺ–ł–Ķ: —Ā–Ľ–Ķ–ī—É–Ķ—ā –Ľ–ł –Ĺ–į—á–ł–Ĺ–į—ā—Ć –Ņ–Ķ—Ä–Ķ–Ľ–ł–≤–į–Ĺ–ł–Ķ —ā—Ä–ĺ–ľ–Ī–ĺ—Ü–ł—ā–ĺ–≤?

–ď–ł—Ā—ā–ĺ–≥—Ä–į–ľ–ľ–į PLT –Ī—č–Ľ–į –ī–į–Ľ–Ķ–ļ–į –ĺ—ā –Ĺ–ĺ—Ä–ľ–į–Ľ—Ć–Ĺ–ĺ–Ļ. –ó–į—ā–Ķ–ľ –ľ—č –Ņ—Ä–ĺ–≤–Ķ—Ä–ł–Ľ–ł –ī–ł–į–≥—Ä–į–ľ–ľ—É —Ä–į—Ā—Ā–Ķ—Ź–Ĺ–ł—Ź RET, –≤ –ļ–ĺ—ā–ĺ—Ä–ĺ–Ļ –Ĺ–į–Ī–Ľ—é–ī–į–Ľ–ĺ—Ā—Ć –Ĺ–Ķ—Ā–ļ–ĺ–Ľ—Ć–ļ–ĺ —ā–ĺ—á–Ķ–ļ PLT, –į —Ā–ĺ–ī–Ķ—Ä–∂–į–Ĺ–ł–Ķ RET –Ī—č–Ľ–ĺ –Ņ–ĺ–≤—č—ą–Ķ–Ĺ–ĺ (–†–ł—Ā. 2).

–≠—ā–ł –į–Ĺ–ĺ–ľ–į–Ľ—Ć–Ĺ—č–Ķ —Ä–Ķ–∑—É–Ľ—Ć—ā–į—ā—č –ĺ–Ī—É—Ā–Ľ–ĺ–≤–ł–Ľ–ł –Ņ—Ä–ł–ľ–Ķ–Ĺ–Ķ–Ĺ–ł–Ķ –Ņ—Ä–į–≤–ł–Ľ–į –Ņ–ĺ–≤—ā–ĺ—Ä–Ĺ–ĺ–≥–ĺ —ā–Ķ—Ā—ā–ł—Ä–ĺ–≤–į–Ĺ–ł—Ź, –Ņ–ĺ—Ā–Ľ–Ķ —á–Ķ–≥–ĺ –Ī—č–Ľ —Ä–į—Ā—Ā–ľ–ĺ—ā—Ä–Ķ–Ĺ –ľ–į–∑–ĺ–ļ –Ņ–Ķ—Ä–ł—Ą–Ķ—Ä–ł—á–Ķ—Ā–ļ–ĺ–Ļ –ļ—Ä–ĺ–≤–ł (–†–ł—Ā. 3). –í —Ä–Ķ–∑—É–Ľ—Ć—ā–į—ā–Ķ –Ī—č–Ľ–ł –Ņ–ĺ–Ľ—É—á–Ķ–Ĺ—č –ī–į–Ĺ–Ĺ—č–Ķ –ĺ –≤–Ĺ—É—ā—Ä–ł—Ā–ĺ—Ā—É–ī–ł—Ā—ā–ĺ–ľ –≥–Ķ–ľ–ĺ–Ľ–ł–∑–Ķ, –≤ —ā–ĺ–ľ —á–ł—Ā–Ľ–Ķ –ĺ —ą–ł—Ā—ā–ĺ—Ü–ł—ā–į—Ö, –Ĺ–Ķ–Ī–ĺ–Ľ—Ć—ą–ĺ–ľ –ļ–ĺ–Ľ–ł—á–Ķ—Ā—ā–≤–Ķ —Ā—Ą–Ķ—Ä–ĺ—Ü–ł—ā–ĺ–≤, —ą–Ľ–Ķ–ľ–ĺ–≤–ł–ī–Ĺ—č—Ö —ć—Ä–ł—ā—Ä–ĺ—Ü–ł—ā–į—Ö –ł —ā—Ä–ĺ–ľ–Ī–ĺ—Ü–ł—ā–ĺ–Ņ–Ķ–Ĺ–ł–ł.
?
–ė—Ā—Ā–Ľ–Ķ–ī–ĺ–≤–į–Ĺ–ł–Ķ –ļ–ĺ—Ā—ā–Ĺ–ĺ–≥–ĺ –ľ–ĺ–∑–≥–į
–≠—Ä–ł—ā—Ä–ĺ—Ü–ł—ā–Ĺ—č–Ķ –ļ–Ľ–Ķ—ā–ĺ—á–Ĺ—č–Ķ –Ľ–ł–Ĺ–ł–ł 44%, –≥—Ä–į–Ĺ—É–Ľ–ĺ—Ü–ł—ā–Ĺ—č–Ķ –ļ–Ľ–Ķ—ā–ĺ—á–Ĺ—č–Ķ –Ľ–ł–Ĺ–ł–ł 40%, G/E=0,91/1.
?
–í –ľ–į–∑–ļ–Ķ –ļ–ĺ—Ā—ā–Ĺ–ĺ–≥–ĺ –ľ–ĺ–∑–≥–į —á–į—Ā—ā–ĺ –≤—Ā—ā—Ä–Ķ—á–į–Ľ–ł—Ā—Ć –Ĺ–Ķ–ī–ł—Ą—Ą–Ķ—Ä–Ķ–Ĺ—Ü–ł—Ä–ĺ–≤–į–Ĺ–Ĺ—č–Ķ —ć—Ä–ł—ā—Ä–ĺ–Ī–Ľ–į—Ā—ā—č –ł –ĺ–Ī–Ĺ–į—Ä—É–∂–ł–≤–į–Ľ–ł—Ā—Ć —ā–Ķ–Ľ—Ć—Ü–į –•–į—É—ć–Ľ–Ľ–į-–Ė–ĺ–Ľ–Ľ–ł. –í—Ā–Ķ–≥–ĺ –≤ –ľ–į–∑–ļ–Ķ –ĺ–Ī–Ĺ–į—Ä—É–∂–Ķ–Ĺ–ĺ 257 –ľ–Ķ–≥–į–ļ–į—Ä–ł–ĺ—Ü–ł—ā–ĺ–≤, 50 –ł–∑ –Ĺ–ł—Ö –ī–ł—Ą—Ą–Ķ—Ä–Ķ–Ĺ—Ü–ł—Ä–ĺ–≤–į–Ĺ–Ĺ—č–Ķ, –≤ —ā–ĺ–ľ —á–ł—Ā–Ľ–Ķ 3 –ľ–Ķ–≥–į–ļ–į—Ä–ł–ĺ–Ī–Ľ–į—Ā—ā–į, 44 –Ņ—Ä–ĺ–ľ–Ķ–≥–į–ļ–į—Ä–ł–ĺ—Ü–ł—ā–į –ł 3 –≥–ĺ–Ľ—č—Ö –ľ–Ķ–≥–į–ļ–į—Ä–ł–ĺ—Ü–ł—ā–į—Ä–Ĺ—č—Ö —Ź–ī—Ä–į. PLT –ĺ–Ī–Ĺ–į—Ä—É–∂–ł–≤–į–Ľ–ł—Ā—Ć —Ä–Ķ–ī–ļ–ĺ. –Ē–į–Ĺ–Ĺ—č–Ļ –ľ–į–∑–ĺ–ļ –ļ–ĺ—Ā—ā–Ĺ–ĺ–≥–ĺ –ľ–ĺ–∑–≥–į –≤—č—Ź–≤–ł–Ľ –ľ–Ķ–≥–į–ļ–į—Ä–ł–ĺ—Ü–ł—ā–į—Ä–Ĺ—É—é —ā—Ä–ĺ–ľ–Ī–ĺ—Ü–ł—ā–ĺ–Ņ–Ķ–Ĺ–ł—é, –Ņ–ĺ–≤—č—ą–Ķ–Ĺ–Ĺ—É—é —Ą—É–Ĺ–ļ—Ü–ł—é —ć—Ä–ł—ā—Ä–ĺ–ł–ī–Ĺ–ĺ–Ļ –ī–ł—Ą—Ą–Ķ—Ä–Ķ–Ĺ—Ü–ł–į—Ü–ł–ł.
?
–ź–Ĺ–į–Ľ–ł–∑ –Ĺ–į –Ī–ł–ĺ—Ö–ł–ľ–ł—é
–ź–Ĺ–į–Ľ–ł–∑ –Ĺ–į –Ī–ł–ĺ—Ö–ł–ľ–ł—é –Ņ–ĺ–ļ–į–∑–į–Ľ –Ņ–ĺ–≤—č—ą–Ķ–Ĺ–Ĺ–ĺ–Ķ —Ā–ĺ–ī–Ķ—Ä–∂–į–Ĺ–ł–Ķ –ĺ–Ī—Č–Ķ–≥–ĺ –Ī–ł–Ľ–ł—Ä—É–Ī–ł–Ĺ–į (TBIL), –Ņ–ĺ–≤—č—ą–Ķ–Ĺ–Ĺ–ĺ–Ķ —Ā–ĺ–ī–Ķ—Ä–∂–į–Ĺ–ł–Ķ —Ā–≤–ĺ–Ī–ĺ–ī–Ĺ–ĺ–≥–ĺ –Ī–ł–Ľ–ł—Ä—É–Ī–ł–Ĺ–į (IBIL), —á—ā–ĺ —Ā–≤–ł–ī–Ķ—ā–Ķ–Ľ—Ć—Ā—ā–≤–ĺ–≤–į–Ľ–ĺ –ĺ –≥–Ķ–ľ–ĺ–Ľ–ł—ā–ł—á–Ķ—Ā–ļ–ĺ–ľ –∑–į–Ī–ĺ–Ľ–Ķ–≤–į–Ĺ–ł–ł.

–£—á–ł—ā—č–≤–į—Ź —ā–ł–Ņ–ł—á–Ĺ–ĺ—Ā—ā—Ć —Ā–ł–ľ–Ņ—ā–ĺ–ľ–ĺ–≤ ‚ÄĒ (1) –≥–Ķ–ľ–ĺ–Ľ–ł—ā–ł—á–Ķ—Ā–ļ–į—Ź –į–Ĺ–Ķ–ľ–ł—Ź (—ą–ł—Ā—ā–ĺ—Ü–ł—ā—č), (2) —ā—Ä–ĺ–ľ–Ī–ĺ—Ü–ł—ā–ĺ–Ņ–Ķ–Ĺ–ł—Ź, (3) –Ĺ–Ķ–≤—Ä–ĺ–Ľ–ĺ–≥–ł—á–Ķ—Ā–ļ–ł–Ķ —Ā–ł–ľ–Ņ—ā–ĺ–ľ—č (—ā—Ä–į–Ĺ–∑–ł—ā–ĺ—Ä–Ĺ—č–Ķ –Ņ—Ā–ł—Ö–ł—á–Ķ—Ā–ļ–ł–Ķ —Ä–į—Ā—Ā—ā—Ä–ĺ–Ļ—Ā—ā–≤–į) ‚ÄĒ –≤–Ķ–Ľ–ł–ļ–į –≤–Ķ—Ä–ĺ—Ź—ā–Ĺ–ĺ—Ā—ā—Ć —ā—Ä–ĺ–ľ–Ī–ĺ—ā–ł—á–Ķ—Ā–ļ–ĺ–Ļ —ā—Ä–ĺ–ľ–Ī–ĺ—Ü–ł—ā–ĺ–Ņ–Ķ–Ĺ–ł–ł (TTP). –†–Ķ–∑—É–Ľ—Ć—ā–į—ā—č –ł —Ä–Ķ–ļ–ĺ–ľ–Ķ–Ĺ–ī–į—Ü–ł–ł –Ņ–ĺ –ī–ł–į–≥–Ĺ–ĺ—Ā—ā–ł–ļ–Ķ TTP –Ī—č–Ľ–ł –Ĺ–Ķ–ľ–Ķ–ī–Ľ–Ķ–Ĺ–Ĺ–ĺ –Ņ–Ķ—Ä–Ķ–ī–į–Ĺ—č –≤—Ä–į—á–į–ľ. –Ē–į–Ľ—Ć–Ĺ–Ķ–Ļ—ą–Ķ–Ķ –į–Ĺ–į–Ľ–ł–∑ –Ĺ–į ADAMTS13 –Ņ–ĺ–ī—ā–≤–Ķ—Ä–ī–ł–Ľ –Ĺ–į–Ľ–ł—á–ł–Ķ TTP. –í –ļ–ĺ–Ĺ–Ķ—á–Ĺ–ĺ–ľ –ł—ā–ĺ–≥–Ķ –≤–ľ–Ķ—Ā—ā–ĺ –Ņ–Ķ—Ä–Ķ–Ľ–ł–≤–į–Ĺ–ł—Ź —ā—Ä–ĺ–ľ–Ī–ĺ—Ü–ł—ā–ĺ–≤ –Ī—č–Ľ–ĺ –Ņ—Ä–ĺ–ł–∑–≤–Ķ–ī–Ķ–Ĺ–ĺ –∑–į–ľ–Ķ—Č–Ķ–Ĺ–ł–Ķ –Ņ–Ľ–į–∑–ľ—č.

–ó–į–ļ–Ľ—é—á–Ķ–Ĺ–ł–Ķ
–ē—Ā–Ľ–ł —Ā–ĺ–ī–Ķ—Ä–∂–į–Ĺ–ł–Ķ PLT –Ĺ–ł–∂–Ķ –Ņ–ĺ—Ä–ĺ–≥–į –Ņ—Ä–ł–Ĺ—Ź—ā–ł—Ź —Ä–Ķ—ą–Ķ–Ĺ–ł—Ź, –ĺ–Ņ—č—ā–Ĺ—č–Ķ –≤—Ä–į—á–ł –Ĺ–Ķ–ľ–Ķ–ī–Ľ–Ķ–Ĺ–Ĺ–ĺ –Ņ–Ķ—Ä–Ķ–Ņ—Ä–ĺ–≤–Ķ—Ä—Ź—é—ā —Ā–ĺ–ĺ—ā–≤–Ķ—ā—Ā—ā–≤–ł–Ķ –ĺ–Ī—Ä–į–∑—Ü–į —É—Ā—ā–į–Ĺ–ĺ–≤–Ľ–Ķ–Ĺ–Ĺ—č–ľ –ļ—Ä–ł—ā–Ķ—Ä–ł—Ź–ľ, —Ā–ĺ–ĺ—ā–≤–Ķ—ā—Ā—ā–≤–ł–Ķ –≥–ł—Ā—ā–ĺ–≥—Ä–į–ľ–ľ—č –ł –ī–ł–į–≥—Ä–į–ľ–ľ—č —Ä–į—Ā—Ā–Ķ—Ź–Ĺ–ł—Ź –Ĺ–ĺ—Ä–ľ–Ķ, –į —ā–į–ļ–∂–Ķ –≤—Ā–Ķ –Ņ—Ä–ĺ—á–ł–Ķ –ĺ—ā–ļ–Ľ–ĺ–Ĺ—Ź—é—Č–ł–Ķ—Ā—Ź –ĺ—ā –Ĺ–ĺ—Ä–ľ—č —Ä–Ķ–∑—É–Ľ—Ć—ā–į—ā—č –Ņ–ĺ–ī—Ā—á–Ķ—ā–į –ļ–Ľ–Ķ—ā–ĺ–ļ, –∑–Ĺ–į—á–ł–ľ—č–Ķ —Ä–Ķ–∑—É–Ľ—Ć—ā–į—ā—č —Ā–ł–≥–Ĺ–į–Ľ–ł–∑–ł—Ä–ĺ–≤–į–Ĺ–ł—Ź –ł?—ā.–ī. –Ē–į–Ľ—Ć–Ĺ–Ķ–Ļ—ą–Ķ–Ķ –Ņ–ĺ–ī—ā–≤–Ķ—Ä–∂–ī–Ķ–Ĺ–ł–Ķ –ĺ—Ā—É—Č–Ķ—Ā—ā–≤–Ľ—Ź–Ķ—ā—Ā—Ź –Ņ—É—ā–Ķ–ľ –ļ–Ľ–ł–Ĺ–ł—á–Ķ—Ā–ļ–ĺ–≥–ĺ –į–Ĺ–į–Ľ–ł–∑–į –ļ—Ä–ĺ–≤–ł –Ņ–ĺ–ī –ľ–ł–ļ—Ä–ĺ—Ā–ļ–ĺ–Ņ–ĺ–ľ. –Ě–į–ļ–ĺ–Ĺ–Ķ—Ü, –Ņ–ĺ—Ā–Ľ–Ķ —Ä–į—Ā—Ā–ľ–ĺ—ā—Ä–Ķ–Ĺ–ł—Ź —Ā–ł–ľ–Ņ—ā–ĺ–ľ–ĺ–≤ –Ņ–į—Ü–ł–Ķ–Ĺ—ā–į –ł –ł—Ā—ā–ĺ—Ä–ł–ł –Ī–ĺ–Ľ–Ķ–∑–Ĺ–ł, –Ľ–į–Ī–ĺ—Ä–į—ā–ĺ—Ä–ł—Ź –ľ–ĺ–∂–Ķ—ā —Ā–ĺ–ĺ–Ī—Č–ł—ā—Ć –ĺ —Ä–Ķ–∑—É–Ľ—Ć—ā–į—ā–į—Ö –ł –Ņ–ĺ—Ā—ā–į–≤–ł—ā—Ć –Ņ—Ä–Ķ–ī–≤–į—Ä–ł—ā–Ķ–Ľ—Ć–Ĺ—č–Ļ –ī–ł–į–≥–Ĺ–ĺ–∑.
?

–ź–≤—ā–ĺ–ľ–į—ā–ł—á–Ķ—Ā–ļ–ł–Ļ 8-–ļ—Ä–į—ā–Ĺ—č–Ļ –Ņ–ĺ–ī—Ā—á–Ķ—ā –ľ–Ķ—ā–ĺ–ī–ĺ–ľ PLT-O (—ā–Ķ—Ö–Ĺ–ĺ–Ľ–ĺ–≥–ł—Ź SF Cube) –ļ–ĺ–ľ–Ņ–į–Ĺ–ł–ł Mindray –ĺ–Ī–Ķ—Ā–Ņ–Ķ—á–ł–≤–į–Ķ—ā —ā–ĺ—á–Ĺ—č–Ļ –ł —Ā—ā–į–Ī–ł–Ľ—Ć–Ĺ—č–Ļ –Ņ–ĺ–ī—Ā—á–Ķ—ā —ā—Ä–ĺ–ľ–Ī–ĺ—Ü–ł—ā–ĺ–≤ –≤ –ĺ–Ī—Ä–į–∑—Ü–į—Ö. –í —Ā–ĺ—á–Ķ—ā–į–Ĺ–ł–ł —Ā –≤—č—Ā–ĺ–ļ–ĺ–ļ–į—á–Ķ—Ā—ā–≤–Ķ–Ĺ–Ĺ—č–ľ –ļ–Ľ–ł–Ĺ–ł—á–Ķ—Ā–ļ–ł–ľ –į–Ĺ–į–Ľ–ł–∑–ĺ–ľ –ļ—Ä–ĺ–≤–ł –≤ SC-120 Auto Slide Maker, –≥–Ķ–ľ–į—ā–ĺ–Ľ–ĺ–≥–ł—á–Ķ—Ā–ļ–ł–Ķ —Ä–Ķ—ą–Ķ–Ĺ–ł—Ź Mindray –Ņ–ĺ–ī–ī–Ķ—Ä–∂–ł–≤–į—é—ā —ć—Ą—Ą–Ķ–ļ—ā–ł–≤–Ĺ–ĺ–Ķ –Ľ–Ķ—á–Ķ–Ĺ–ł–Ķ —ā—Ä–ĺ–ľ–Ī–ĺ—Ü–ł—ā–ĺ–Ņ–Ķ–Ĺ–ł–ł. –ú–Ķ—ā–ĺ–ī PLT-O —Ä–Ķ–į–Ľ–ł–∑–ĺ–≤–į–Ĺ –≤ –į–≤—ā–ĺ–ľ–į—ā–ł—á–Ķ—Ā–ļ–ĺ–ľ –≥–Ķ–ľ–į—ā–ĺ–Ľ–ĺ–≥–ł—á–Ķ—Ā–ļ–ĺ–ľ –į–Ĺ–į–Ľ–ł–∑–į—ā–ĺ—Ä–Ķ —Ā–Ķ—Ä–ł–ł Mindray BC-6000 –ł —Ā–ł—Ā—ā–Ķ–ľ–Ķ —Ü–ł—ā–ĺ–Ľ–ĺ–≥–ł—á–Ķ—Ā–ļ–ĺ–≥–ĺ –į–Ĺ–į–Ľ–ł–∑–į CAL 8000/6000.
?
–Ē–ĺ–Ņ–ĺ–Ľ–Ĺ–Ķ–Ĺ–ł–Ķ. –ü–ĺ—á–Ķ–ľ—É –Ņ–Ķ—Ä–Ķ–Ľ–ł–≤–į–Ĺ–ł–Ķ —ā—Ä–ĺ–ľ–Ī–ĺ—Ü–ł—ā–ĺ–≤ –Ĺ–Ķ —Ä–Ķ–ļ–ĺ–ľ–Ķ–Ĺ–ī—É–Ķ—ā—Ā—Ź –Ņ—Ä–ł —ā—Ä–ĺ–ľ–Ī–ĺ—ā–ł—á–Ķ—Ā–ļ–ĺ–Ļ —ā—Ä–ĺ–ľ–Ī–ĺ—Ü–ł—ā–ĺ–Ņ–Ķ–Ĺ–ł–ł?
?
–ě–Ī—Č–ł–Ķ –Ņ—Ä–ł—á–ł–Ĺ—č —ā—Ä–ĺ–ľ–Ī–ĺ—Ü–ł—ā–ĺ–Ņ–Ķ–Ĺ–ł–ł –≤–ļ–Ľ—é—á–į—é—ā —Ā–Ĺ–ł–∂–Ķ–Ĺ–ł–Ķ –≤—č—Ä–į–Ī–ĺ—ā–ļ–ł —ā—Ä–ĺ–ľ–Ī–ĺ—Ü–ł—ā–ĺ–≤ –≤ –ļ–ĺ—Ā—ā–Ĺ–ĺ–ľ –ľ–ĺ–∑–≥–Ķ, —É–≤–Ķ–Ľ–ł—á–Ķ–Ĺ–ł–Ķ —Ä–į–∑—Ä—É—ą–Ķ–Ĺ–ł—Ź —ā—Ä–ĺ–ľ–Ī–ĺ—Ü–ł—ā–ĺ–≤ –≤ –Ņ–Ķ—Ä–ł—Ą–Ķ—Ä–ł—á–Ķ—Ā–ļ–ĺ–Ļ –ļ—Ä–ĺ–≤–ł, –į —ā–į–ļ–∂–Ķ –ľ–Ķ–ī–ł–ļ–į–ľ–Ķ–Ĺ—ā–ĺ–∑–Ĺ–ĺ–Ķ –Ľ–Ķ—á–Ķ–Ĺ–ł–Ķ[1].
?
–Ę—Ä–ĺ–ľ–Ī–ĺ—ā–ł—á–Ķ—Ā–ļ–į—Ź —ā—Ä–ĺ–ľ–Ī–ĺ—Ü–ł—ā–ĺ–Ņ–Ķ–Ĺ–ł—Ź, –≤ —ā–ĺ–ľ —á–ł—Ā–Ľ–Ķ –ł TTP –≤ —Ä–į—Ā—Ā–ľ–ĺ—ā—Ä–Ķ–Ĺ–Ĺ–ĺ–ľ —Ā–Ľ—É—á–į–Ķ, —Ź–≤–Ľ—Ź–Ķ—ā—Ā—Ź –ĺ–ī–Ĺ–ĺ–Ļ –ł–∑ –Ī–ĺ–Ľ–Ķ–∑–Ĺ–Ķ–Ļ, –≤—č–∑—č–≤–į–Ķ–ľ—č—Ö –Ņ–ĺ–≤—č—ą–Ķ–Ĺ–Ĺ—č–ľ —Ä–į–∑—Ä—É—ą–Ķ–Ĺ–ł–Ķ–ľ PLT. –ė–∑-–∑–į –ī–Ķ—Ą–ł—Ü–ł—ā–į –Ņ—Ä–ĺ—ā–Ķ–į–∑—č —Ä–į—Ā—Č–Ķ–Ņ–Ľ–Ķ–Ĺ–ł—Ź (ADAMTS13) —Ą–į–ļ—ā–ĺ—Ä–į —Ą–ĺ–Ĺ –í–ł–Ľ–Ľ–Ķ–Ī—Ä–į–Ĺ–ī–į (VWF), VWF –Ĺ–Ķ –ľ–ĺ–∂–Ķ—ā –Ĺ–ĺ—Ä–ľ–į–Ľ—Ć–Ĺ–ĺ –ĺ—ā–ī–Ķ–Ľ—Ź—ā—Ć—Ā—Ź, —á—ā–ĺ –Ņ—Ä–ł–≤–ĺ–ī–ł—ā –ļ –Ĺ–į–ļ–ĺ–Ņ–Ľ–Ķ–Ĺ–ł—é —Ā–≤–Ķ—Ä—Ö–Ī–ĺ–Ľ—Ć—ą–ł—Ö VWF (ULVWF), —á—ā–ĺ –≤ —Ā–≤–ĺ—é –ĺ—á–Ķ—Ä–Ķ–ī—Ć –≤—č–∑—č–≤–į–Ķ—ā –į–Ĺ–ĺ–ľ–į–Ľ—Ć–Ĺ—É—é –į–≥—Ä–Ķ–≥–į—Ü–ł—é PLT, –ľ–ł–ļ—Ä–ĺ—ā—Ä–ĺ–ľ–Ī–ĺ–∑ –ł —Ą—Ä–į–≥–ľ–Ķ–Ĺ—ā–į—Ü–ł—é RBC[2]. –í —ā–į–ļ–ĺ–Ļ —Ā–ł—ā—É–į—Ü–ł–ł –Ņ–Ķ—Ä–Ķ–Ľ–ł–≤–į–Ĺ–ł–Ķ —ā—Ä–ĺ–ľ–Ī–ĺ—Ü–ł—ā–ĺ–≤ –ľ–ĺ–∂–Ķ—ā —É—Ā–ļ–ĺ—Ä–ł—ā—Ć —ā—Ä–ĺ–ľ–Ī–ĺ–ĺ–Ī—Ä–į–∑–ĺ–≤–į–Ĺ–ł–Ķ, —á—ā–ĺ –Ņ—Ä–ł–≤–Ķ–ī–Ķ—ā –ļ —É—Ö—É–ī—ą–Ķ–Ĺ–ł—é —Ā–ł–ľ–Ņ—ā–ĺ–ľ–ĺ–≤[3]. –ü–ĺ—ć—ā–ĺ–ľ—É –Ņ—Ä–ł —ā—Ä–ĺ–ľ–Ī–ĺ—ā–ł—á–Ķ—Ā–ļ–ĺ–Ļ —ā—Ä–ĺ–ľ–Ī–ĺ—Ü–ł—ā–ĺ–Ņ–Ķ–Ĺ–ł–ł –ĺ—Ā–Ĺ–ĺ–≤–Ĺ–ĺ–Ļ —ā–Ķ—Ä–į–Ņ–ł–Ķ–Ļ –ī–ĺ–Ľ–∂–Ĺ–ĺ –Ī—č—ā—Ć –∑–į–ľ–Ķ—Č–Ķ–Ĺ–ł–Ķ –Ņ–Ľ–į–∑–ľ—č.
?
–Ď–Ľ–į–≥–ĺ–ī–į—Ä—Ā—ā–≤–Ķ–Ĺ–Ĺ–ĺ–Ķ —Ā–Ľ–ĺ–≤–ĺÔľö
–í—č—Ä–į–∂–į–Ķ–ľ –Ī–Ľ–į–≥–ĺ–ī–į—Ä–Ĺ–ĺ—Ā—ā—Ć –ī–ĺ–ļ—ā–ĺ—Ä—É –°—Ź–ĺ –¶–∑—É–ĺ–ľ—Ź–ĺ, –ī–ĺ–ļ—ā–ĺ—Ä—É –ß—ć–Ĺ—Ć –°—Ź–Ĺ—Ć—á—É–Ĺ—Ć, –ī–ĺ–ļ—ā–ĺ—Ä—É –°—Ź–ĺ –Ē—ć—Ü–∑—é–Ĺ—Ć –ł –ī–ĺ–ļ—ā–ĺ—Ä—É –õ–ĺ –®–ł –ł–∑ –Ě–į—Ä–ĺ–ī–Ĺ–ĺ–Ļ –Ī–ĺ–Ľ—Ć–Ĺ–ł—Ü—č –ď–į–Ĺ—Ć—á–∂–ĺ—É, –ö–ł—ā–į–Ļ, –∑–į –Ņ—Ä–Ķ–ī–ĺ—Ā—ā–į–≤–Ľ–Ķ–Ĺ–Ĺ—É—é –ł–Ĺ—Ą–ĺ—Ä–ľ–į—Ü–ł—é –ĺ –ļ–Ľ–ł–Ĺ–ł—á–Ķ—Ā–ļ–ĺ–ľ —Ā–Ľ—É—á–į–Ķ.
–°—Ā—č–Ľ–ļ–ł:
[1] What Is Thrombocytopenia??- NHLBI, NIH". www.nhlbi.nih.gov. –Ē–į—ā–į –ĺ–Ī—Ä–į—Č–Ķ–Ĺ–ł—Ź: 2015-05-01.
[2] Tsai, Han-Mou (2010). ‚ÄúPathophysiology of thrombotic thrombocytopenic purpura.‚ÄĚ
International journal of hematology vol. 91,1: 1-19. doi:10.1007/s12185-009-0476-1.
[3] Joly, BS; Coppo, P; Veyradier, A (2017). "Thrombotic thrombocytopenic purpura." Blood. 129 (21): 2836‚Äď2846. doi:10.1182/blood-2016-10-709857.














